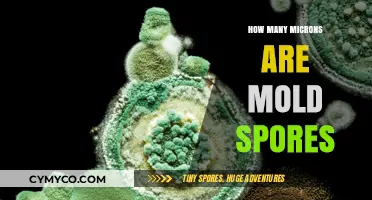
Unveiling the Microscopic World: The Size of Mold Spores

Mold spores are incredibly resilient and can travel far and wide, often carried by air currents, water, or even insects. Their ability to disperse is crucial for their survival and reproduction, allowing them to colonize new environments and thrive in various conditions. Understanding the extent of their travel is essential for managing mold growth and preventing its spread in both indoor and outdoor settings.
| Characteristics | Values |
|---|---|
| Distance | Mold spores can travel up to several kilometers in the air. |
| Viability | Mold spores can remain viable for months or even years in dry conditions. |
| Dispersal Methods | Mold spores are dispersed through the air, water, and soil. |
| Size | Mold spores are typically between 3-100 micrometers in size. |
| Shape | Mold spores can be round, oval, or irregularly shaped. |
| Color | Mold spores can be colorless, white, green, black, or brown. |
| Growth Conditions | Mold spores require moisture, oxygen, and a suitable substrate to grow. |
| Health Effects | Inhaling mold spores can cause respiratory problems, allergic reactions, and other health issues. |
| Detection Methods | Mold spores can be detected through air sampling, surface sampling, and bulk sampling. |
| Remediation Methods | Mold spores can be removed through cleaning, disinfection, and mold remediation techniques. |
Explore related products
$13.48 $14.13
What You'll Learn
- Airborne Transmission: Mold spores can become airborne and travel through ventilation systems, spreading throughout a building
- Water Dispersal: Spores can be carried by water, especially in areas with high humidity or water damage, facilitating their spread
- Surface Contact: Mold spores can adhere to surfaces like clothing, shoes, and pets, allowing them to be transported to new locations
- Insect and Animal Vectors: Certain insects and animals can carry mold spores on their bodies, aiding in their dispersal over various distances
- Human Interaction: People can inadvertently transfer mold spores from one area to another through touch or by moving contaminated items

Airborne Transmission: Mold spores can become airborne and travel through ventilation systems, spreading throughout a building
Mold spores are incredibly lightweight and can easily become airborne, posing a significant risk to indoor air quality. When disturbed, mold colonies release spores into the air, which can then be carried by air currents throughout a building's ventilation system. This process is particularly concerning in large buildings with extensive ductwork, as spores can travel long distances before settling in new locations.
The ability of mold spores to travel through ventilation systems is influenced by several factors, including the type of mold, the size and concentration of spores, and the airflow dynamics within the building. For example, Aspergillus and Penicillium spores are among the most common types found in indoor environments and can remain airborne for extended periods due to their small size and lightweight nature.
Once airborne, mold spores can be distributed throughout a building, potentially leading to the establishment of new mold colonies in areas with suitable growth conditions. This can result in a widespread mold infestation, which may be difficult and costly to remediate. Furthermore, the inhalation of mold spores can cause respiratory issues and allergic reactions in sensitive individuals, highlighting the importance of preventing airborne transmission.
To mitigate the risk of airborne mold spore transmission, it is essential to maintain proper ventilation and air filtration systems. Regular cleaning and inspection of ducts and vents can help prevent the buildup of mold and reduce the likelihood of spores being dispersed throughout the building. Additionally, the use of HEPA filters can effectively capture mold spores, preventing them from being recirculated into the indoor environment.
In conclusion, the airborne transmission of mold spores is a critical concern for building owners and occupants. By understanding the factors that influence spore travel and implementing effective prevention strategies, it is possible to minimize the risk of mold infestations and maintain a healthy indoor environment.
Identifying Black Mold Spores on Leather: Appearance and Characteristics
You may want to see also
Explore related products
$9.48 $9.98

Water Dispersal: Spores can be carried by water, especially in areas with high humidity or water damage, facilitating their spread
Mold spores are incredibly resilient and can travel far and wide in search of a suitable environment to grow. One of the primary means of dispersal for these spores is through water. In areas with high humidity or water damage, mold spores can be carried by water droplets, facilitating their spread to new locations. This is particularly concerning in indoor environments, where water damage can create a conducive environment for mold growth.
The process of water dispersal begins when mold spores come into contact with water. The spores are then carried by the water droplets as they move through the air or along surfaces. This can happen through splashing, spraying, or even condensation. In areas with high humidity, mold spores can be carried by water vapor, allowing them to travel even further.
The distance that mold spores can travel through water dispersal depends on a number of factors, including the size of the water droplets, the velocity of the water, and the environmental conditions. In general, smaller water droplets can carry spores further than larger droplets, as they are more likely to remain suspended in the air. Similarly, spores can travel further in environments with high humidity or low air circulation.
One of the most common ways that mold spores are dispersed through water is through flooding. When a building is flooded, mold spores can be carried by the water into new areas, leading to widespread mold growth. This is particularly concerning in areas with high humidity, as the spores can continue to spread even after the water has receded.
To prevent mold growth in areas with high humidity or water damage, it is important to take steps to reduce the amount of moisture in the environment. This can include using dehumidifiers, fixing leaks, and improving air circulation. Additionally, it is important to clean up any water damage quickly and thoroughly to prevent mold spores from taking hold.
In conclusion, water dispersal is a significant means of mold spore dispersal, particularly in areas with high humidity or water damage. By understanding the process of water dispersal and taking steps to reduce moisture in the environment, it is possible to prevent mold growth and maintain a healthy indoor environment.
From Syringe to Harvest: A Beginner's Guide to Growing Mushroom Spores
You may want to see also
Explore related products

Surface Contact: Mold spores can adhere to surfaces like clothing, shoes, and pets, allowing them to be transported to new locations
Mold spores are incredibly adept at attaching themselves to various surfaces, which serves as a primary mechanism for their dispersal. This ability to adhere to surfaces like clothing, shoes, and even pets allows mold spores to be transported over considerable distances, facilitating their spread to new environments. For instance, spores can latch onto the fabric of clothing and remain there until the garment is washed or dry cleaned, potentially carrying the spores to different locations in the process.
Similarly, shoes can act as a vector for mold spore transportation. Spores can adhere to the soles or other parts of shoes, particularly if they have come into contact with moldy surfaces. As individuals walk, these spores can be transferred to new areas, including indoor spaces where they might not have been present otherwise. This highlights the importance of regularly cleaning and disinfecting shoes, especially after walking in areas known to have mold growth.
Pets, too, can inadvertently carry mold spores. The fur or paws of pets can pick up spores from moldy surfaces, which can then be deposited in other locations as the pet moves around. This is particularly concerning for households with pets that spend time outdoors, as they may inadvertently introduce mold spores into the home environment. Regular grooming and cleaning of pets can help mitigate this risk.
The implications of mold spores' ability to adhere to surfaces and be transported are significant. It means that even if a mold problem is contained in one area, the spores can still spread to other parts of a building or even to different buildings. This underscores the importance of comprehensive mold remediation strategies that not only address the source of the mold but also take steps to prevent the spread of spores to new locations.
In conclusion, the surface contact of mold spores is a critical factor in their ability to travel and colonize new areas. By understanding how spores adhere to and are transported by surfaces like clothing, shoes, and pets, we can better develop strategies to prevent their spread and protect indoor environments from mold growth.
Where to Purchase Milky Spore: A Comprehensive Guide
You may want to see also
Explore related products

Insect and Animal Vectors: Certain insects and animals can carry mold spores on their bodies, aiding in their dispersal over various distances
Insects and animals play a significant role in the dispersal of mold spores. These vectors can carry spores on their bodies, facilitating their spread over various distances. For instance, certain species of beetles, such as the carpet beetle, are known to transport mold spores from one location to another. Similarly, rodents like mice and rats can also act as vectors, spreading spores through their fur and droppings.
The distance that mold spores can travel via insect and animal vectors depends on several factors, including the species of the vector, its habitat, and its behavior. For example, beetles that inhabit human dwellings may spread spores within a building, while those that live outdoors may disperse spores over a wider area. Rodents, on the other hand, can travel long distances in search of food and shelter, potentially spreading spores across vast areas.
In addition to the direct dispersal of spores, insects and animals can also contribute to the spread of mold by creating conditions that favor mold growth. For instance, rodents can cause damage to buildings, leading to water intrusion and creating an environment conducive to mold growth. Similarly, insects like termites can create tunnels and burrows that trap moisture, promoting the growth of mold.
To mitigate the spread of mold spores by insect and animal vectors, it is essential to implement effective pest control measures. This may include sealing entry points to prevent rodents and insects from entering buildings, using traps and baits to control pest populations, and maintaining a clean and dry environment to discourage mold growth.
In conclusion, insects and animals are important vectors for the dispersal of mold spores, and their role should not be overlooked in efforts to control mold growth. By understanding the behavior and habitat of these vectors, it is possible to develop effective strategies for preventing the spread of mold and protecting human health.
How Long Do Spore Prints Last: A Comprehensive Guide
You may want to see also
Explore related products

Human Interaction: People can inadvertently transfer mold spores from one area to another through touch or by moving contaminated items
Human interaction plays a significant role in the spread of mold spores. When individuals touch surfaces contaminated with mold, the spores can adhere to their skin and clothing, allowing them to be carried to other areas. This transfer can occur through direct contact with moldy surfaces or by handling items that have been exposed to mold. For instance, if someone touches a moldy wall and then touches a clean surface, they can inadvertently transfer the spores, potentially leading to new mold growth if the conditions are favorable.
The risk of mold spore transfer through human interaction is particularly high in environments with high humidity and poor ventilation, as these conditions are conducive to mold growth. In such settings, it is crucial to take precautions to minimize the spread of mold spores. This can include wearing protective gear such as gloves and masks when handling moldy materials, as well as ensuring that surfaces are properly cleaned and disinfected to prevent the growth of mold.
One common mistake people make is not realizing the extent to which mold spores can travel. They may assume that mold is only a local problem, confined to the area where it is visible. However, mold spores are microscopic and can easily become airborne, traveling through the air to new locations. This means that even if mold is only present in one part of a building, the spores can spread to other areas, potentially leading to widespread contamination.
To prevent the spread of mold spores through human interaction, it is important to educate individuals about the risks and take steps to mitigate them. This can include providing training on proper cleaning and disinfection techniques, as well as implementing policies to ensure that moldy materials are handled safely. By taking these steps, it is possible to reduce the risk of mold spore transfer and prevent the spread of mold to new areas.
In conclusion, human interaction is a key factor in the spread of mold spores. By understanding the risks and taking appropriate precautions, it is possible to minimize the transfer of mold spores and prevent the growth of mold in new areas. This requires a combination of education, proper cleaning and disinfection techniques, and the use of protective gear when handling moldy materials.
Lysol's Effectiveness Against Ringworm Spores: A Comprehensive Guide
You may want to see also
Frequently asked questions
Mold spores can travel significant distances through the air, depending on various factors such as wind speed, humidity, and the type of mold. Some spores can travel miles, while others may only travel a few feet.
The distance mold spores can travel is influenced by several factors, including wind speed and direction, humidity levels, the type of mold, and the presence of other airborne particles. Higher wind speeds and humidity can help spores travel farther, while certain types of mold may produce spores that are more resilient and capable of long-distance travel.
Yes, mold spores can also travel through water. Some types of mold, such as those that grow in aquatic environments, produce spores that are adapted to water dispersal. These spores can travel through water currents, potentially spreading the mold to new locations.